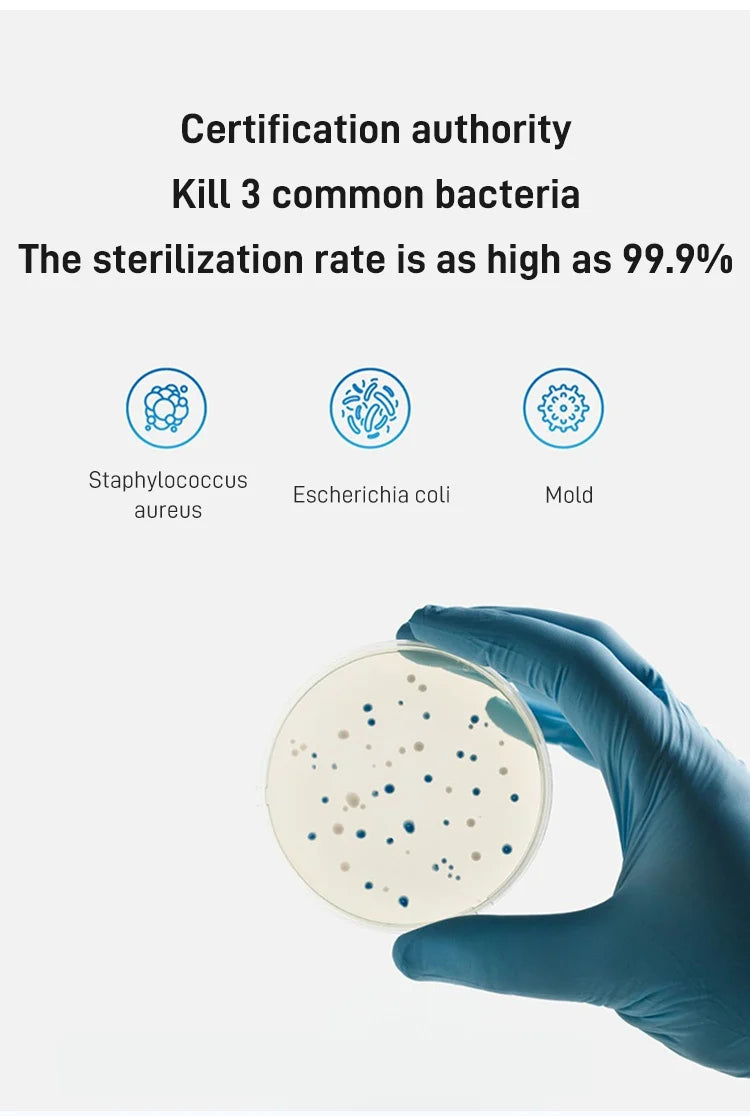
Home Smart Mini Vacuum Cleaner Usb Charging Automatic Smart Sweeping Robot Cleaning Machine

Zoom

Certification: None
Choice: yes
High-concerned chemical: None
Origin: Mainland China













From handpicked sellers
Delivery in 24 hours max!
100% secure payments
Add multi-buy discount
Dedicated 24/7 Support
From handpicked sellers
Wishlist is empty.